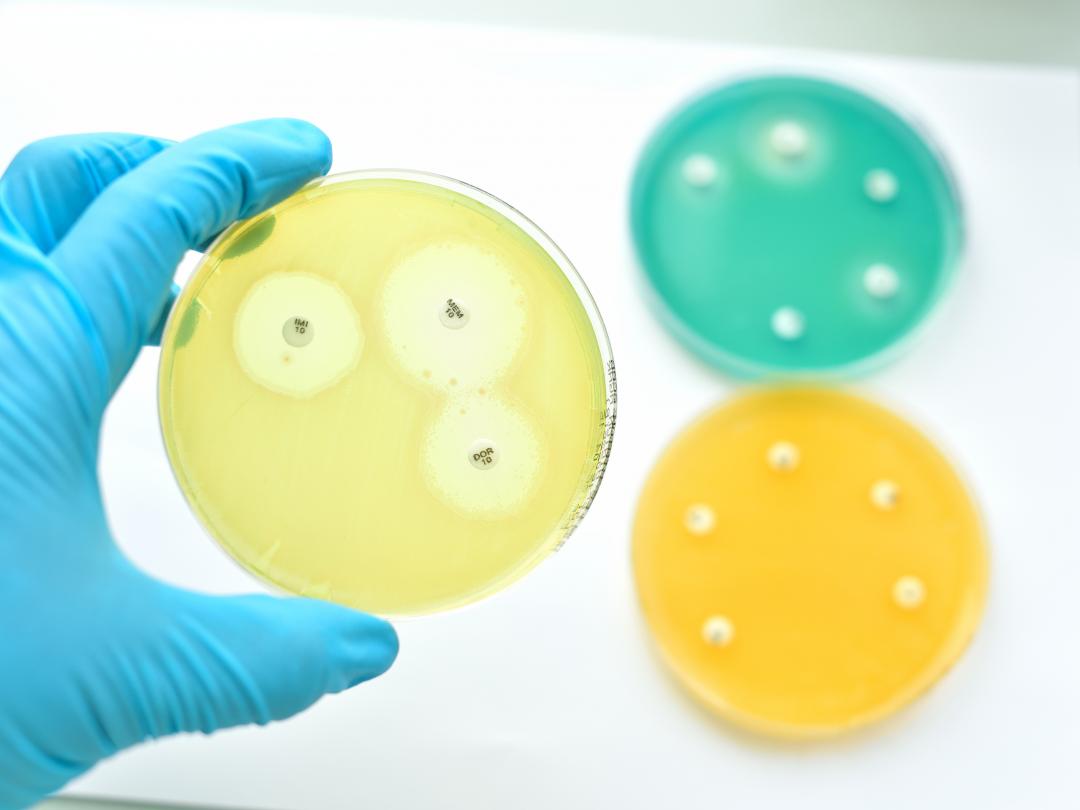
Drie petrischaaltjes.

De definitie van de categorie I (‘intermediair gevoelig’) in het antibiogram is gewijzigd naar ‘gevoelig bij verhoogde blootstelling’. Deze wijziging heeft consequenties voor de praktijk. In dit artikel lichten wij die wijziging toe en laten we zien wat de consequenties zijn.
Samenvatting
De betekenis van de categorie I in het antibiogram verandert momenteel landelijk. Voorheen betekende de I-categorie ‘intermediair gevoelig’ en omvatte zij combinaties van antibiotica en micro-organismen waarbij de kans op therapeutisch succes niet te voorspellen was. De categorie werd in de praktijk beschouwd als ‘in dit geval onduidelijk’ en antibiotica in deze categorie werden in de praktijk dan ook vaak vermeden. Met ingang van 2019 heeft de European Committee on Antimicrobial Susceptibility Testing (EUCAST) de definitie van I veranderd naar ‘gevoelig bij verhoogde blootstelling’. Zoals de naam zegt biedt de nieuwe I altijd een reële behandeloptie, zolang men het antibioticum hoger doseert dan de standaarddosis. Niet alle microbiologische laboratoria zullen deze nieuwe I gelijktijdig invoeren en de wijze waarop zij dat doen kan ook in detail verschillen. Overleg met uw arts-microbioloog of antibioticateam als u twijfelt of uw medisch microbiologisch laboratorium de nieuwe definitie van I heeft doorgevoerd of twijfelt over de juiste dosering.

Reacties